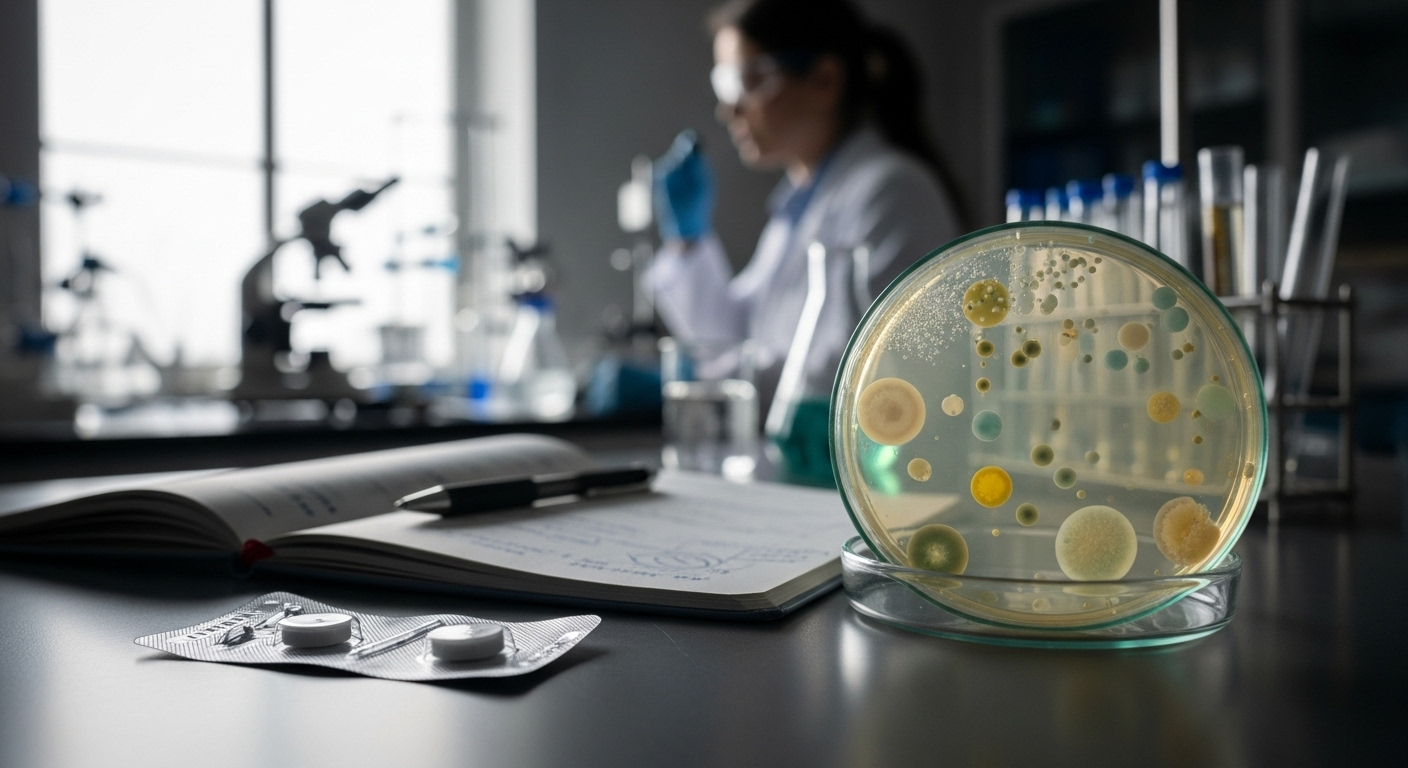
Cancer : l’aspirine pourrait-elle devenir un traitement révolutionnaire ?

On la connaît pour un simple mal de tête, un début de fièvre. Et pourtant, la modeste aspirine pourrait bien bouleverser le traitement d’un des cancers les plus redoutables. Une étude d’envergure, publiée dans la prestigieuse revue New England Journal of Medicine, révèle qu’une faible dose quotidienne divise par deux le risque de récidive du cancer colorectal pour une partie des patients opérés. Une nouvelle qui redonne espoir, là où on ne l’attendait pas.
Une intuition enfin confirmée par la science

L’aspirine, plus que centenaire, n’en finit pas de surprendre. L’idée qu’elle puisse jouer un rôle protecteur contre certains cancers n’est pas tout à fait nouvelle ; des études observationnelles semaient le doute, et l’espoir, depuis des années. Mais il manquait la preuve, l’essai clinique solide capable de transformer l’intuition en certitude médicale. Ce chaînon manquant vient peut-être d’être trouvé.
ALASCCA, l'étude qui change la donne

Cette preuve, c’est l’étude ALASCCA qui semble l’apporter. Menée dans une trentaine d’hôpitaux en Suède, Norvège, Danemark et Finlande, elle a suivi plus de 3 500 personnes opérées d’un cancer du côlon ou du rectum. La méthode était simple et rigoureuse : pendant trois ans, un groupe a reçu 160 mg d’aspirine par jour, l’autre un simple placebo, sans que ni les patients ni les médecins ne sachent qui prenait quoi. Les résultats parlent d’eux-mêmes.
La clé : une simple mutation génétique

Mais voilà le point crucial : le traitement n’est pas pour tout le monde. Son efficacité spectaculaire ne concerne qu’un groupe bien précis : les patients dont la tumeur présente une mutation sur un gène appelé PI3K, soit environ un tiers des cas. Chez eux, le risque de voir la maladie revenir a chuté de 14 % à seulement 7,7 %. Comme le souligne la professeure Anna Martling, qui a supervisé l’étude, « c’est un exemple clair de médecine de précision », où la génétique guide le traitement.
Quand la science rencontre la vie réelle

Concrètement, qu’est-ce que cela signifie ? Imaginons un patient, appelons-le Paul, 62 ans, opéré et porteur de cette fameuse mutation. Hier, il vivait avec une chance sur sept de rechuter dans les trois ans. Aujourd’hui, avec un comprimé à quelques centimes par jour, ce risque est quasiment divisé par deux. C’est la perspective d’éviter une nouvelle chimiothérapie, ses effets lourds, et de reprendre une vie plus sereine.
Un rappel nécessaire sur le cancer colorectal

Il est bon de rappeler de quoi l’on parle. Ce cancer, l’un des plus fréquents, naît souvent de petites excroissances, les polypes, sur la paroi de l’intestin. Les signaux d’alerte – troubles du transit, saignements inexpliqués, fatigue anormale – ne doivent jamais être ignorés. L’âge, les antécédents familiaux ou encore l’alimentation jouent un rôle. Mais la bonne nouvelle, c’est que dépisté à temps, via un test ou une coloscopie, il se guérit dans neuf cas sur dix.
Prudence et perspectives d'avenir

Malgré l’enthousiasme, les médecins appellent à la raison. Prescrire de l’aspirine à tous serait une erreur potentiellement dangereuse. Le médicament fluidifie le sang et augmente le risque de saignements, parfois graves. L’étude elle-même le montre : 16,8 % des patients sous aspirine ont connu des complications hémorragiques, contre 11,6 % dans le groupe placebo. Pas question, donc, de se lancer dans l’automédication.
vers une médecine de précision pour tous ?

L’enjeu est désormais ailleurs. Pour que cette découverte profite au plus grand nombre, il faudra rendre le test génétique pour la mutation PI3K accessible et systématique après le diagnostic. Si cet obstacle est levé, l’aspirine pourrait bien devenir l’un des premiers exemples d’un traitement de précision à la fois efficace, bon marché et, finalement, démocratisé. Une petite révolution née d’un très vieux comprimé.
Selon la source : passeportsante.net










